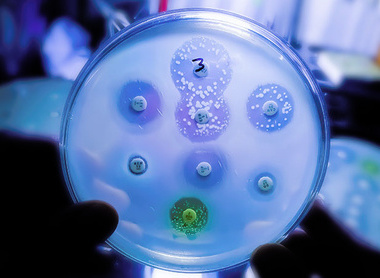
October 2023 Bulletin Banner.jpg

College Bulletin
We cater for the interests of our diverse readership, provoking discussion and comment on topics that range across the 17 specialties of pathology.
The January Bulletin explores paediatric pathology. The issue features articles on the impact of oral microbiology on dental health and the challenges faced in paediatric infection practice and laboratory medicine. The issue also includes updates on primary immune deficiencies, childhood vaccination and innovations in paediatric pathology, with an introduction from the Children’s Commissioner.
The issue includes articles on optimising clinical consultations, the impact of cyber-attacks on pathology services and the launch of the statutory medical examiner system. The Bulletin also reports on the Wales Pathology Symposium, National Pathology Week and International Pathology Day.
In his editorial, Dr Bernie Croal welcomes the new year by reflecting on the vital importance of paediatric pathology. Dr Croal notes the concerns around workforce capacities in healthcare services and highlights the upcoming plans that aim to transform pathology and healthcare. The President concludes by reinforcing that innovation and collective responsibility will ensure successful patient care in future.